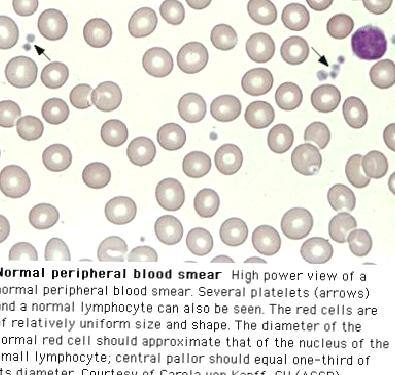
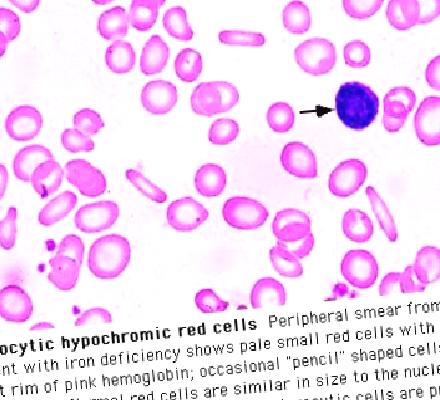
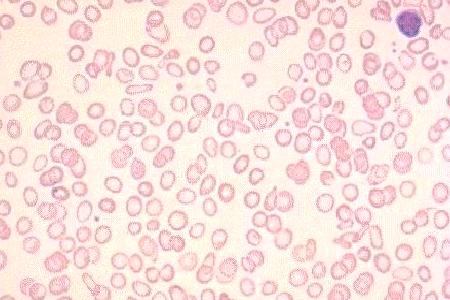

Demir Eksikliği Anemisi
Demir eksikliği anemisi (DEA) – Çocuklarda en sık görülen besinsel eksiklik – WHO verilerine göre DEA 500 milyonla 2 milyar arasında …

Demir eksikliği anemisi (DEA)
– Çocuklarda en sık görülen besinsel eksiklik
– WHO verilerine göre DEA 500 milyonla 2 milyar arasında insanı etkiliyor
– Bazı gelişmekte olan ülkelerde okul öncesi çocukların ve hamile kadınların %50’sinde DEA var
Demir metabolizması
– Demir insanlar için çok gerekli bir elementdir
– Demirin %75’i myoglobin ve hemoglobine bağlı olarak, gerisi ise depo proteinleri olan ferritin ve hemosiderine bağlı olarak bulunur. %3 kadarı ise katalaz ve sitokoromlar gibi kritik enzim sistemlerinin içindedir
– NormaI bireylerde sadece küçük bir miktar demir günlük olarak vücuda girer ve çıkar. Demirin büyük kısmı yaşlı eritrositlerin karaciğer ve dalak makrofajları tarafından parçalanmasından gelir
Demir dengesi
– Demir dengesi barsaktan emilim, transport proteinleri ve duodenal demir taşıyıcıları ile sağlanır.İdrar ve dışkı ile atılımın daha az rolü vardır
– Erişkinlerde günlük demir gereksiniminin %5’i diyetle alınır ve bu miktar gastrointestinal sistem’den kaybedilen demire eşdeğerdir
– Süt çocuklarında ve çocuklarda büyüme ve kas kütlesinde artma nedeniyle günlük gereksinimin %30’u diyetten alınmak zorundadır
– Barsaktan demir emilimini etkileyen 3 faktör vardır: 1-vücut demir depoları (transferrin ve ferritin), 2-eritropoetik (kan yapım ) hız, 3-diyetteki demirin biyoyararlılığı
– Düşük demir depoları varlığında ince barsak mukozasında reseptörlerin artması ile demir emilimi artar. Emilim aynı zamanda eritropoez arttığında, retikülositoz varlığında veya ineffektif eritropoez varlığında da artma gösterir
– Hem kaynaklı demir’in (balık kümes hayvanları ve kırmızı et) biyolojik yararlılığı non-hem kaynaklı demirden (sebzeler) daha fazladır (%30 vs %10). Ayrıca intraluminal faktörler de emilimi etkilerler
– C vit tahıllar, ekmek, meyve ve sebzeler gibi non-hem kaynaklı demirin emilimini artırır. Çaydaki tannatlar, fosfattan zengin gıdalar ve fitatlar demir emilimini engeller
Demir metabolizmasının gelişimsel süreci
– Doğumda term bebekler yaklaşık 75 mg/kg demir deposu ile doğarlar. Bu demirin 2/3’ü hemoglobin ile bağlı durumdadır. Eğer doğumda normal hemoglobin miktarına erişilememişse (ortalama 15 to 17 gm/dL) bu durum direk olarak depolar dışındaki demiri etkiler ve yaşamın ilk 3-6 ayında DEA riski artar
– İlk 5-6 ay sırasında normal term bebek demir açısından zengin durumdadır. Ancak yenidoğan dönemindeki bazı durumlar erken DEA gelişmesine neden olabilir:
– Prematürite
– Prematürite anemisi için eritropoietin (EPO) kullanılması
– Fetal-maternal kanama
– İkizden ikize transfüzyon sendromu
– Diğer perinatal hemorajik olaylar
– Diyetle yetersiz alım
– Prematüreler doğumda daha düşük kan volümüne sahip olduklarından erken süt çocukluğu döneminde DEA riski ile karşı karşıyadırlar. Aynı zamanda flebotomi ile kayıplar ve ferritin miktarlarındaki düşüklüğe rağmen GİS den demir emiliminin zayıf olması da erken DEA riskini artıran faktörlerdir
– Prematürite anemisinin önlenmesi veya tedavisi için EPO kullanılması DEA riskini daha da artırır
– Erken süt çocukluğu ve çocukluk döneminde DEA gelişmesine katkıda bulunan diyetle ilgili faktörler:
– Yetersiz demir alımı
– Yetersiz demir emilimi
– İnek sütünün erken başlanması
– İnek sütü intoleransına bağlı olarak gizli kan kaybı (eksudatif enteropati)
– İlaçlar (örn; aspirin, nonsteroidal antiinflamatuar ilaçlar)
– Malabsorpsiyon durumları
Besinsel gereksinim
– Term bebekte günde 1 mg/kg demir, maksimum 15 mg (%10’unun emildiği farzedilerek)
– Pretermlerde, düşük Hb ile doğanlarda, anlamlı kan kaybı yaşayanlarda 2mg/kg, maks. 15 mg.
Demir eksikliği anemisinin nedenleri
– Yetersiz alım (inek sütü 0.5-1.5mg Fe/L)
– Artmış gereksinim (büyüme, syanotik konjenital kalp hastalığı)
– Kan kaybı
– Perinatal (placental, göbekten)
– Postnatal (Gİ yol: DEA kendisi barsaklarda değişiklik yaparak kan kaybını artırır, inek sütü hipersensitivitesi, anatomik lezyonlar, aspirin gastriti, parazitler, HSP)
– Gİ yol: hepatobilier sistem: hepatobilia
– Akciğer: pulmoner hemosideroz, Goodpasture send.
– Burun: tekrarlayan burun kanaması
– Uterus: menstrual kayıp
– Kalp:intrakardiak miksomata, valvüler protezler veya yamalar
– Böbrek:mikroanjiopatik hemolitik anemi, hematüri, nefrotik sendrom, PNH,vs.
– Ekstrakorporeal: hemodiyaliz, travma
– Emilimde bozukluk: malabsorbsiyon sendromları, çöliak hastalığı, IBD, helikobakter nedenli kronik gastrit)
DEA için risk faktörleri
– Düşük doğum ağırlığı
– Prematürite
– Çoğul gebelik
– Hızlı büyüme
– Kronik hipoksi
– Doğumda düşük Hb
– Kan kaybı (perinatal kanama)
– Diyet faktörleri:
– erken inek sütü
– erken katı gıda
– düşük demirli mamalar
– çok çay içilmesi
– düşük vit C alımı
– az et yenmesi
– 6 aydan uzun emzirme ve demir verilmemesi
– Düşük sosyoekonomik düzey: sık enfeksiyonlar
Büyüme
– Her bir kg tartı artışı vücut demirinde 35-45 mg artmayı gerektirir
– YD da 75mg/kg Fe var
– Eğer diyette Fe yoksa veya kan kaybı varsa term bebekte 6 aya pretermde 3-4 aya varmadan bu Fe biter
Kan kaybı
– DEA’nin kendisi barsaktan gizli kan kaybına neden olur
– DEA’li bebeklerin %50sinden fazlasında dışkıda kan bulunur
– Bu kan demirin barsaktaki enzim sistemlerindeki eksikliği ile meydana gelir
– Ayrıca eksudatif enteropati de olur. Sadece eritrositler değil diğer hücreler ve protein de kaybedilir
– İnek sütü de eksudatif enteropati yapar
İnek sütüne bağlı demir eksikliği
– Günde 500 ml den fazla İS içilmesi
– Hipoproteinemi ve hipokupremi olması
– Hipokalsemi, hipotransferrinemi, düşük serum Ig leri olması
– Diğer nedenlerle açıklanamayan DEA
– Demir tedavisine yeterli cevaptan sonra tekrarlayan DEA
– Hızlı gelişen ağır DEA
– Oral demir tedavisine yetersiz cevap olması
– Gros kanama veya diğer anatomik nedenlerin yokluğunda dışkıda sürekli gizli kan bulunması
– İS’nin kesilmesi ile barsak işlevlerinin ve DEA’nin hızla düzelmesi
Emilim bozukluğu
– Generalize malabsorbsiyon sendromu DEA’nin seyrek görülen bir nedenidir
– Daha çok DEA barsak mukozasına etki ederek sadece demirin değil ksiloz, yağ ve vitamin A nı da emilimini bozar
DEA’nin nonhematolojik bulguları
– Anoreksi (sık ve erken bulgu)
– Pika (pakofaji:buz, jeofaji:kum)
– Atrofik glossit
– Disfaji
– Esofageal ağ
– Gastrik asiditede azalma
– Sızıntılı barsak sendromu (leaky gut)
– Malabsorbsiyon sendromu
– Azalmış sitokrom oksidaz aktivitesi
– Disakkaridaz aktivitesinde azalma ve laktoz intoleransı
– Artmış kadmiyum ve kurşun emilimi
– Barsak geçirgenlik indeksinde artma
– İrritabilite
– Yorgunluk ve aktivite azalması
– Mental ve motor gelişimde gerilik
– Dikkat ve konsantrasyon eksikliği
– Okul başarısında belirgin azalma
– Nefes tutma atakları
– Papilla ödemi
– İnfeksiyonlara eğilimin artması (solunum yolu enf. larına eğilimin artması ve iyileşmede gecikme)
– Lökosit transformasyonunun bozulması
– Granülositlerin öldürme ve NBT reaksiyonlarının bozulması
– İnce barsak lökositlerinde myeloperoksidaz azalması
– Deri hipersensitivitesinde azalma
Tanı
Hb yaşa uygun düzeylerin altına düşer MCV, MCH ve MCHC azalır Hipokromik ve mikrositik eritrositler, anizositoz, poikilositoz (Hb<10gr/dL) RDW artar (>%14.5) Retikülosit sayısı genellikle normal, kanamayla birlikte giden ağır DEA de artar Ağır DEA’de trombositopeni Beraberinde barsaktan kanama varsa trombositoz FEP artar (kurşun zehirlenmesinde çok daha yüksektir). FEP artışı daha mikrositik anemi gelişmeden oluşur ve demir tedavisi için endikasyon oluşturur Ferritin depoların düzeyini yansıtır. Kronik enflamasyon, bakteriyel veya parazitik enf., malignensi sırasında artar Demir ve demir bağlama kapasitesi hassas olmayan testlerdir. Demirin normal değerleri çok değişkendir, günlük değişimlerden, diyetteki demirden, yaştan çok etkilenir, geçici veya hafif enfeksiyonlarda düşer Serum transferrin reseptör düzeyleri hassas bir testdir. Eritrosit öncüllerinin artması ile artar. Kronik enfeksiyon durumlarından etkilenmez. Bu nedenle ayırıcı tanıda kullanılır. ELİSA yöntemi ile ölçülür Eritrosit çinko protoporfirini/hem oranı:demir yetmezlğinde protoporfirinle çinko birleşir. Bu nedenle oran artar. Ferritinden daha hassas bir testtir. Kronik enfeksiyondan etkilenmez
Ayırıcı tanı
– Hipokromiye birlikte olan durumlar:
– demir eksikliği
– hemoglobinopatiler (talasemi,Hb E, Hb H, Hb lepore ve köln)
– kimyasallarla bozulan hem sentezi (kurşun, pirazinamid, INH)
– sideroblastik anemiler
– Hipokromiye birlikte olan durumlar:
– kronik enfeksiyonlar veya iltihabi durumlar
– malinite
– herediter orotik asidüri
– hipo veya atransferrinemi (konjenital-akkiz)
– bakır eksikliği
– demir metabolizmasının doğuştan bozuklukları

Besinsel destek
– En az 6 ay anne sütü alımı
– 1 yaşına kadar demir takviyeli mama
– İS kullanımının 500 ml ile sınırlanması
– Demirle zenginleştirilmiş tahılların 1 yaşına kadar kullanılması
– İS hassasiyeti varsa soya bazlı mamalar
– Düşük doğum ağırlıklı bebeklere Fe desteği
– Demirden zengin besinlerin (et, balık tavuk, meyveler) diyete eklenmesi
– Demir emilimini engelleyen çay, fosfat ve fitatların verilmemesi
Tedavi
– Demirin ferrous tuzları verilmeli, ferrik tuzlarının emilimi iyi değil
– Günde 1.5-2mg/kg x3
– Barsak intoleransı olanlarda gün aşırı verilmesi daha iyi
– Hb düzeyi ve eritrosit endeksleri normale döndükten sonra 6-8 hafta daha verilmeli
– 5.-10. günde retik. cevabı olur
– Bunu takiben ilk 7 günde Hb günde 0.25-0.4 kadar artar, daha sonra 0.1-0.15 artış olur
– Yetersiz cevap: komplians düşüklüğü, yetersiz doz, etkisiz ilaç, inatçı kan kaybı, yanlış tanı, eşlik eden hastalık, emilim bozukluğu
Parenteral tedavi
– İM: demir dekstran: etkin, emniyetli ve iyi tolere edilir
– Endikasyonları: oral demir ile komplians bozukluğu, ağır barsak hastalığı, kronik kanama, akut diareal bozukluk
– Doz: (normal Hb-başlangıç HB)/100 x kan v(ml)x3.4×1.5
İM tedavi yan etkileri
– İM enjeksiyon yerinde renk değişikliği
– Lokal enflamasyon (seyrek)
– Bulantı ve sersemlik hissi (seyrek)






